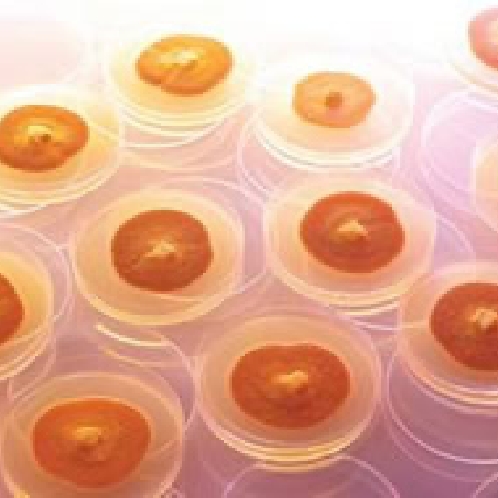
独自の栽培技術

独自の製造・栽培方法
アントロキノノールの製造方法
1000キログラムの菌糸体から
わずか1キログラム(0.1%)
抽出されるアントロキノノール
アントロキノノールはベニクスノキタケからごく少量抽出されます。まずベニクスノキタケの菌糸体1,000キログラムを低温凍結乾燥し、粉砕します。この時点で粉末は200キログラムにまで圧縮されます。
次に、この粉末から独自の製法でエキスを超臨界抽出し、約10分の1の16リットルまで凝縮します。
アントロキノノール含有エキスはこの16リットルに含有されている成分で主に構成され、アントロキノノールをはじめ、βグルカン、トリペルテン類が含まれております。

最後に、この16リットルのアントロキノノール含有エキスよりβグルカン、トリペルテン類等の成分を取り除くと、純粋なアントロキノノールが1リットル抽出されます。
このような過程で抽出されたアントロキノノールはわずか1リットルです。ベニクスノキタケ菌糸体1,000キログラムのわずか0.1%です。


菌糸体1,000kg
低音凍結乾燥し粉砕

粉末200gまでに圧縮

余分成分を取り除き純粋な
アントロキノノール1Lを抽出

独自の製法でエキスを
超臨界抽出し16Lまで凝縮

ベニクスノキタケの希少性
ベニクスノキタケは、世界でも台湾だけに自生しているという大変めずらしいきのこです。学名は「Antrodia camphorata(アントロディア・カンフォラタ)」といいます。サルノコシカケと同じ科で原産地の台湾では「樟子(しょうし)」と呼ばれています。その色は鮮紅色から褐色で、希少性から「森のルビー」「森の宝石」などと呼ばれています。
生息するのは海抜500メートル以上の高山のみで、クスノキ科の牛樟樹(ぎゅうしょうじゅ)という樹木に寄生します。若木には生えず、樹齢100年を超える老木の洞(うろ、幹の空洞の意味)に寄生します。 食用のきのことは違い1年で1ミリメートル程度しか成長しないため、乱獲によってたちまち絶滅寸前となり、台湾政府が国を挙げて保護に乗り出しています。
乱獲を防ぐため採集が厳しく規制されている今、野生のベニクスノキタケは1キログラム200万円以上の値段がついており、事実上入手が不可能な状態となっております。
そのため、ベニクスノキタケを独自で栽培・培養する技術が求められており、仙樹堂のアントロキノノール含有エキスは長年にわたり培われてきた栽培技術により、ベニクスノキタケを量産しております。

独自の栽培技術
アントロキノノールを安定して抽出するために、大量のベニクスノキタケを安定して栽培する技術が不可欠になります。当社の販売するアントロキノノールの研究チームは、独自の製法でベニクスノキタケを培養することに成功しました。
ベニクスノキタケの菌糸体を穀物などの固体培地で3か月かけて発酵させるという固体発酵という特殊な栽培方法を取っております。これにより、安定して大量のベニクスノキタケの栽培が実現し、アントロキノノール含有エキスを商品化させることに成功しました。
もちろん、安全面には最大の配慮がなされており、安心してお召しいただけます。安全性につきましてはこちらをご参照ください。
ベニクスノキタケ菌糸体
1,000キログラムのわずか0.1%
このように、アントロキノノールはベニクスノキタケに含まれるわずか0.1%の成分のため、ベニクスノキタケを大量に摂取してもアントロキノノールはほとんど摂取できません。
アントロは、一粒あたり3ミリグラム以上のアントロキノノールを配合し、効率よくアントロキノノールを摂取していただける構成となっております。



